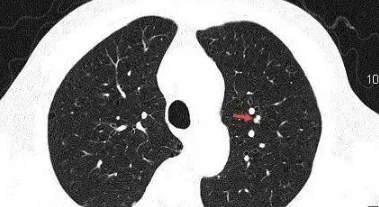
肺部有结节是怎么回事？要紧吗？

肺部有结节是怎么回事?6mm的肺结节要紧吗?
6毫米的肺结节一般不严重,8毫米以下的肺结节称为小结节。如果6毫米肺结节无毛刺、分叶、胸膜凹陷征、空泡征、血管征等恶变征象,多为肺部感染所致,不太严重。除肺部感染外,还可能由肺结核、陈旧性肺部病灶或肺结节病引起。如果是由这些原因引起的,一般来说并不严重。
极少数可由肺部恶性肿瘤引起,如出现了毛刺、分叶、胸膜凹陷征、空泡血管征等等。在这种情况下,有必要进一步明确诊断。肺结节6mm应首先考虑肺部感染,抗感染两周后即可复查。如果没有变化,则有必要定期复查,尤其是40岁以上、长期吸烟、长期处于二手烟环境中、或有恶性肿瘤家族史的患者。如果在复查过程中发现某些恶变迹象,必须进一步检查,以便早期诊断和治疗。